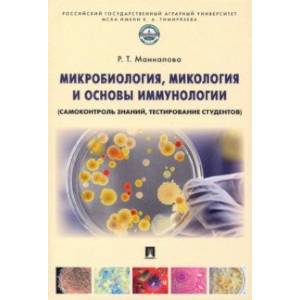

Все наши посылки проходят обеззараживание!
Оно предназначено для самоконтроля знаний студентами при подготовке к занятиям, коллоквиумам, зачетам, итоговому и интернет-контролю. Состоит из двух глав: тренажера для самоконтроля знаний по теоретическому материалу и тестового контроля для освоения материала лабораторно-практических занятий. Темы изложены по единому плану, что облегчает пользование учебным пособием, усвоение и прочное закрепление материала. В конце книги представлен терминологический словарь, а также сведения об основоположниках микробиологии и лауреатах Нобелевской премии по микробиологии и иммунологии.
Как оформить заказ
Оформить заказ на нашем сайте легко. Просто добавьте выбранные товары в корзину, а затем перейдите на страницу Корзина, проверьте правильность заказанных позиций и нажмите кнопку «Оформить заказ».
Оформление заказа
Если вы уверены в выборе, то можете самостоятельно оформить заказ, заполнив по этапам всю форму.
Заполнение адреса
Выберите из списка название вашего региона и населённого пункта. Если вы не нашли свой населённый пункт в списке, выберите значение «Другое местоположение» и впишите название своего населённого пункта в графу «Город». Введите правильный индекс.
Доставка
В зависимости от места жительства вам предложат варианты доставки. Выберите любой удобный способ. Подробнее об условиях доставки читайте в разделе «Доставка».
Оплата
Выберите оптимальный способ оплаты. Подробнее о всех вариантах читайте в разделе «Оплата»
Покупатель
Введите данные о себе: ФИО, адрес доставки, номер телефона. В поле «Комментарии к заказу» введите сведения, которые могут пригодиться курьеру, например: подъезды в доме считаются справа налево.
Оформление заказа
Проверьте правильность ввода информации: позиции заказа, выбор местоположения, данные о покупателе. Нажмите кнопку «Оформить заказ».
Наш сервис запоминает данные о пользователе, информацию о заказе и в следующий раз предложит вам повторить к вводу данные предыдущего заказа. Если условия вам не подходят, выбирайте другие варианты.
Вы можете выбрать один из вариантов оплаты:
PayPal (оплата online)

Для оплаты вы можете воспользоваться электронной международной платёжной системой PayPal. Вас перенаправит на страницу платежного сервиса, следуя инструкциям, заполните форму.
Банковский перевод

При оформлении заказа в корзине вы можете выбрать вариант оплаты банковский перевод. Вам будет в автоматическом режиме предоставлены реквизиты для оплаты через банк вашего заказа.
Почтовая доставка DHL

Мы доставляем все товары через службу доставки DHL
Срок доставки
От 12-17 рабочих дней в зависимости от наличия товара на складе, количество заказываемых книг (позиций) и загруженности службы доставки.